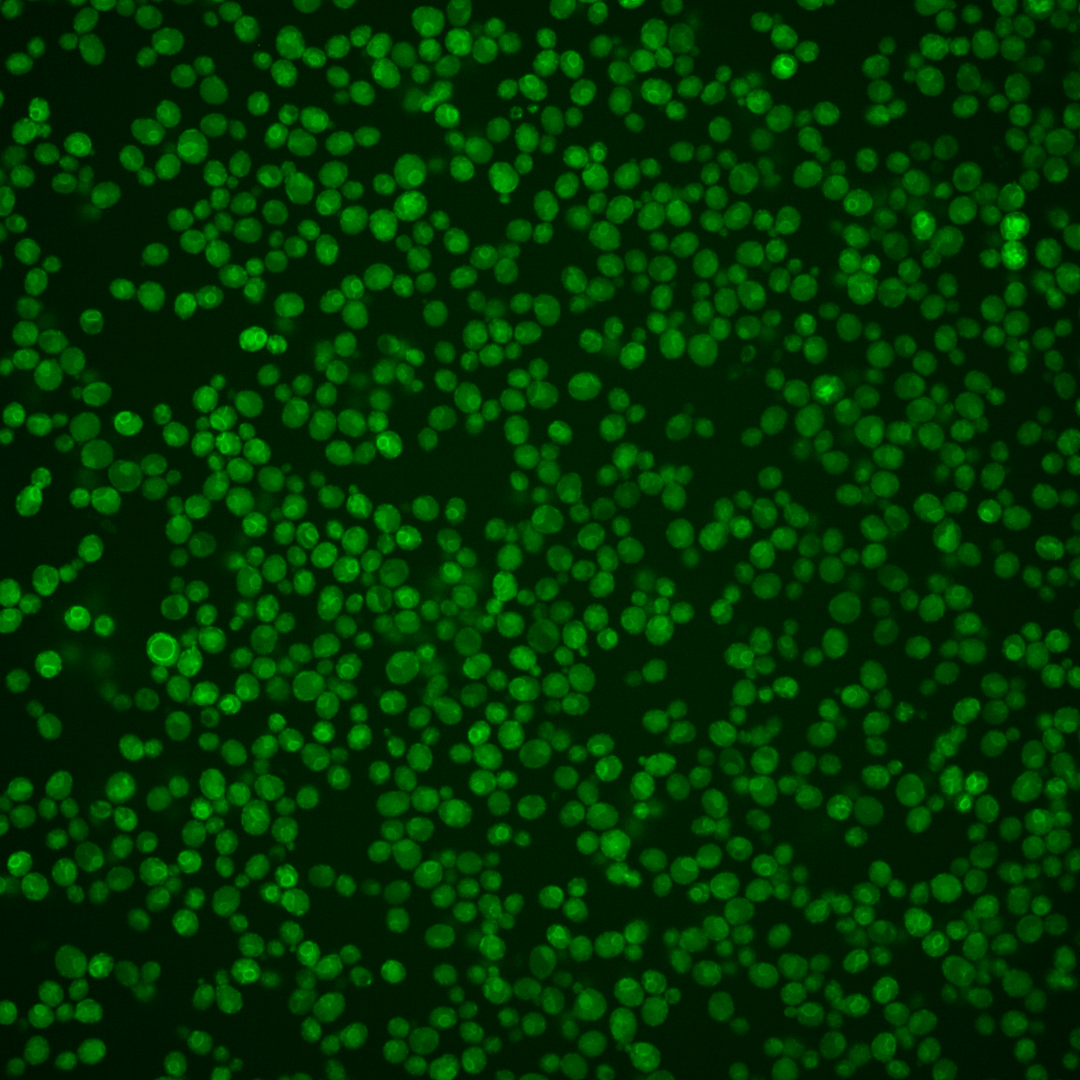
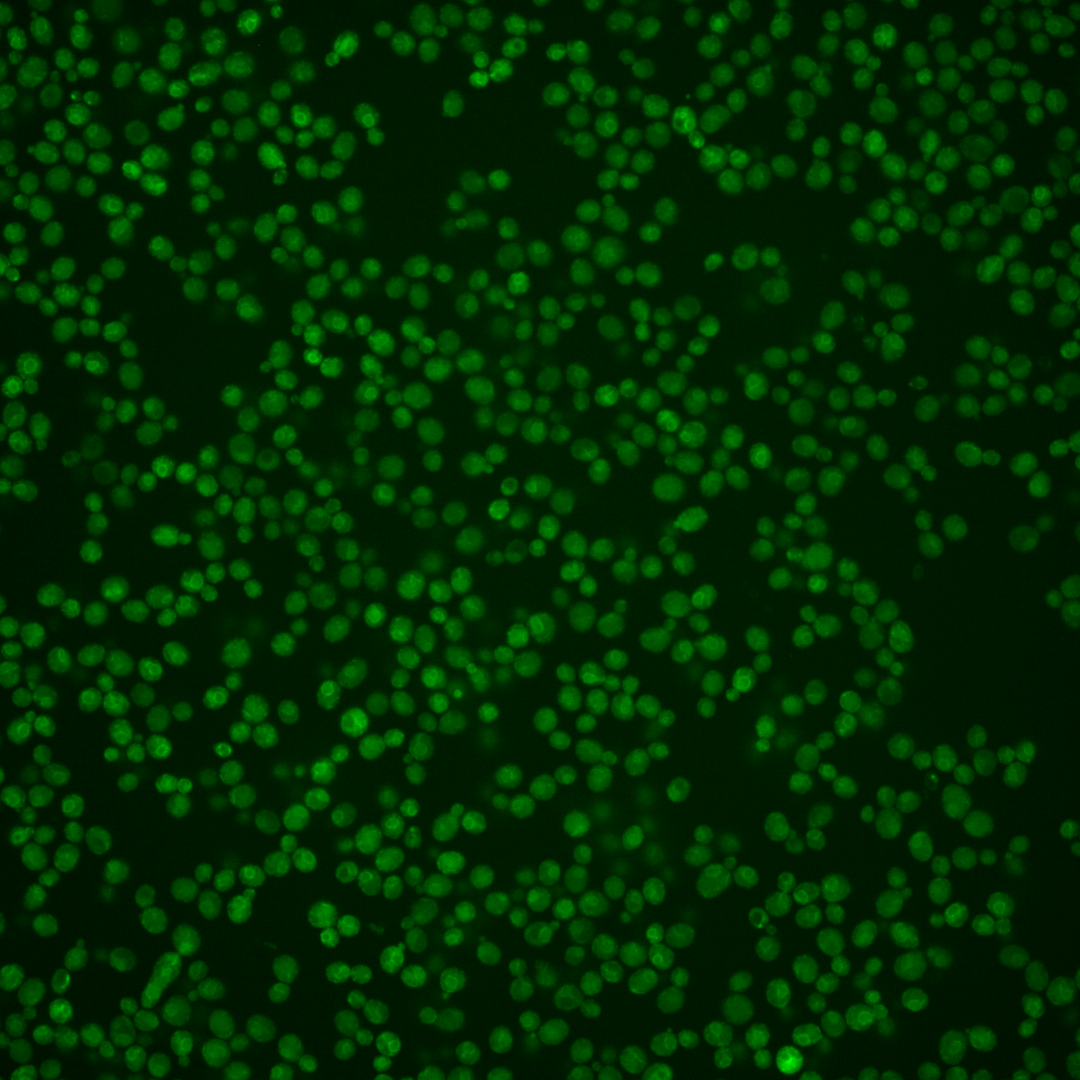
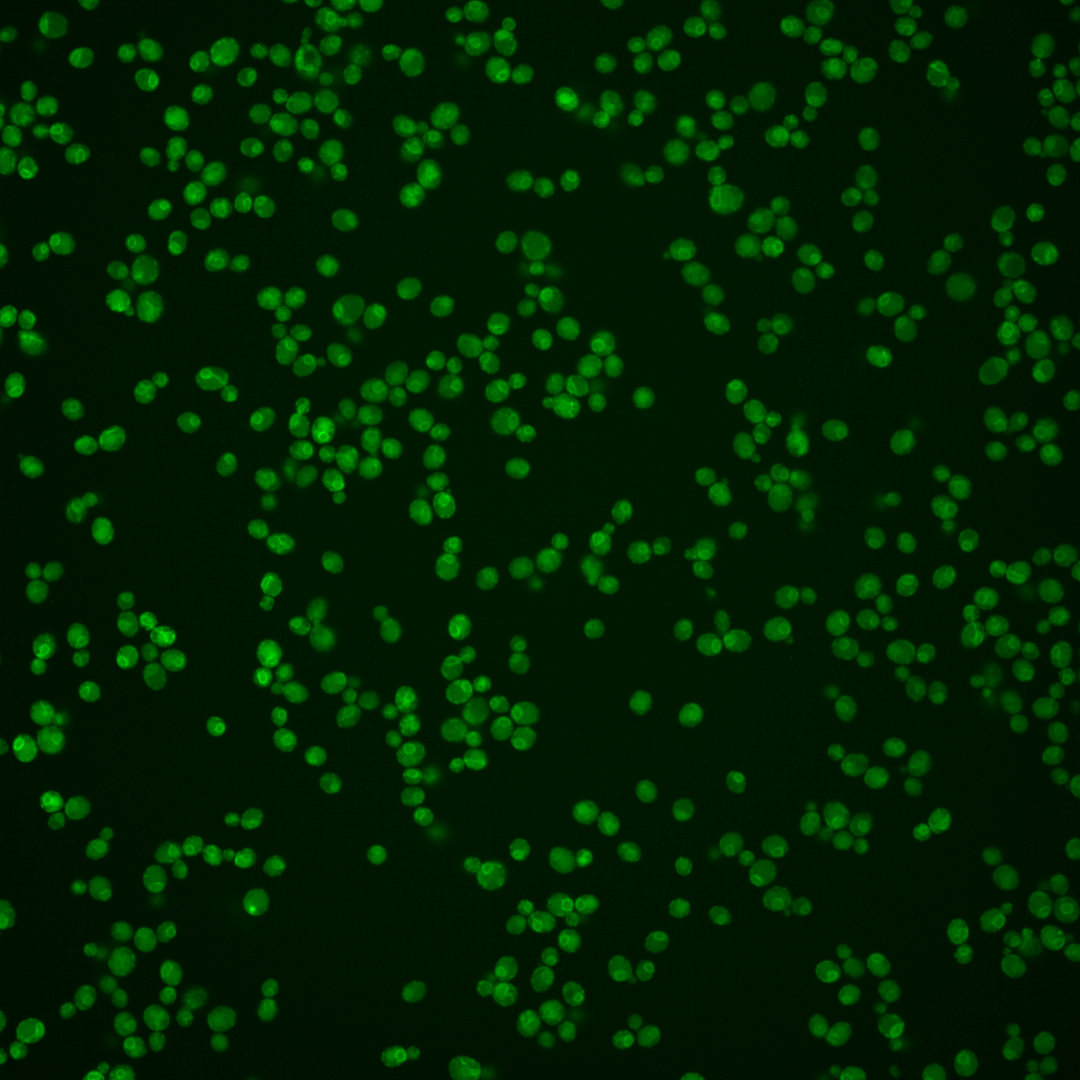
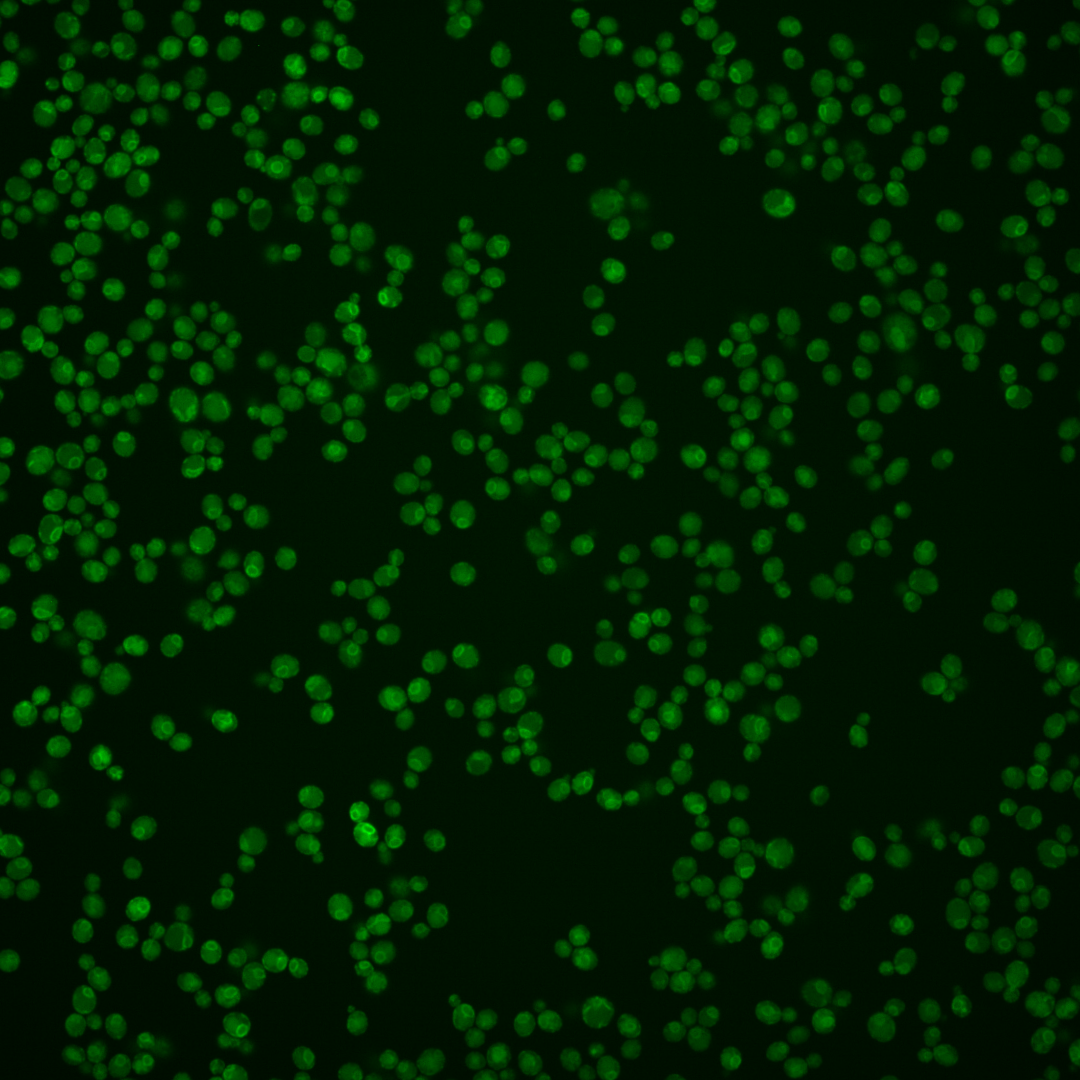
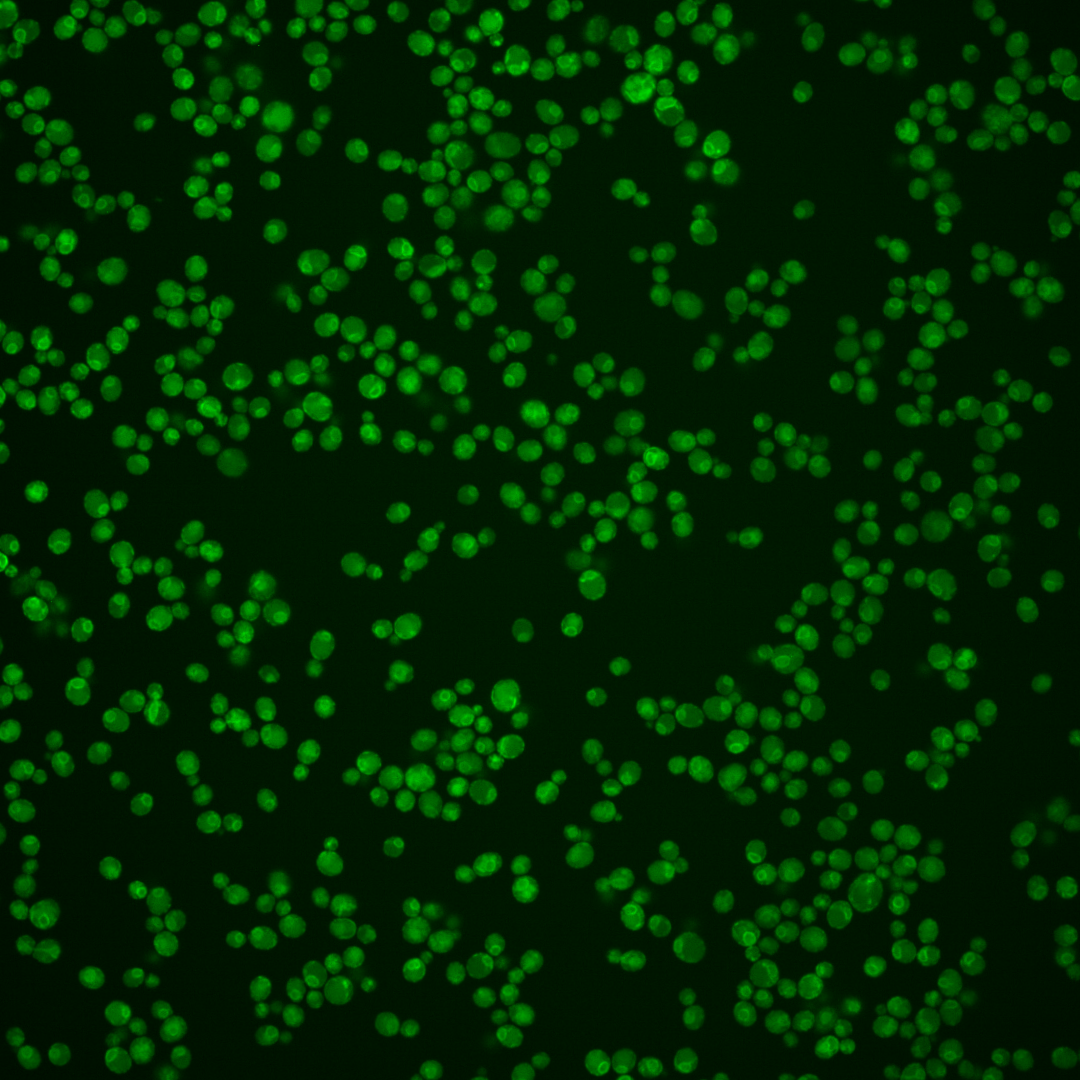
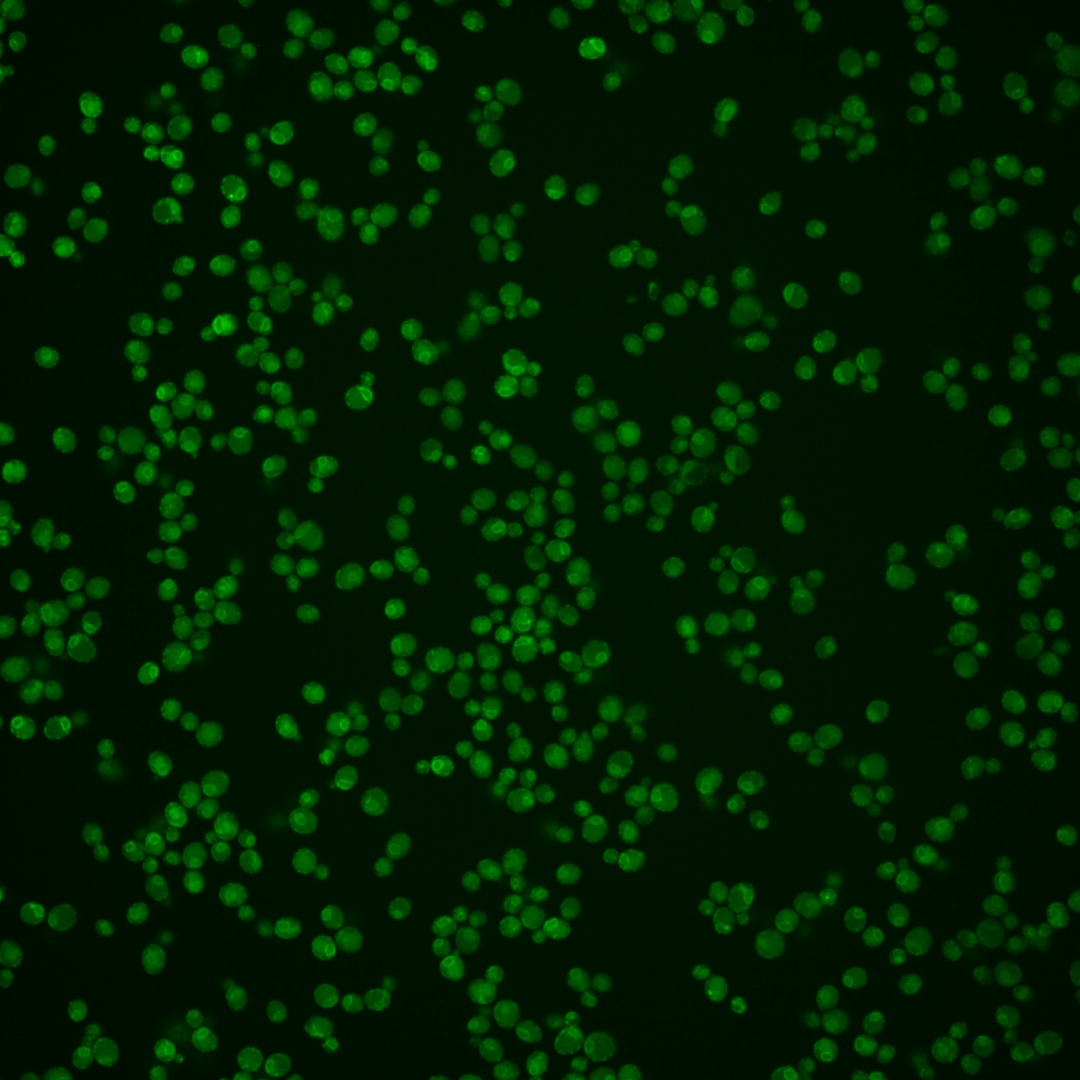

| Standard name | |
|---|---|
| Human Ortholog | |
| Description | Putative divalent metal ion transporter involved in iron homeostasis; transcriptionally regulated by metal ions; member of the Nramp family of metal transport proteins; protein abundance increases in response to DNA replication stress |
Micrographs




















































































Sub-cellular Localization
Yeast GFP Assignment
Protein Abundance
Localization Change
External localization resources
| ensLOC | DeepLoc | |||||||||||||||||||||||
|---|---|---|---|---|---|---|---|---|---|---|---|---|---|---|---|---|---|---|---|---|---|---|---|---|
| Localization | WT1 | WT2 | WT3 | RAP60 | RAP140 | RAP220 | RAP300 | RAP380 | RAP460 | RAP540 | RAP620 | RAP700 | HU80 | HU120 | HU160 | rpd3Δ_1 | rpd3Δ_2 | rpd3Δ_3 | WT1 | WT2 | WT3 | AF100 | AF140 | AF180 |
| Cortical Patches | 0 | 0 | 0 | 0 | 0 | 0 | 0 | 0 | 0 | 0 | 0 | 0 | 23 | 9 | 1 | 0 | 0 | 0 | 0 | 0 | 2 | 1 | 2 | 2 |
| Bud | 0 | 0 | 0 | 0 | 0 | 0 | 1 | 1 | 0 | 0 | 1 | 0 | 1 | 1 | 0 | 0 | 0 | 0 | 0 | 1 | 0 | 2 | 1 | 4 |
| Bud Neck | 0 | 0 | 0 | 0 | 0 | 0 | 0 | 0 | 0 | 0 | 0 | 0 | 0 | 0 | 0 | 0 | 0 | 0 | 0 | 0 | 0 | 0 | 0 | 1 |
| Bud Site | 0 | 0 | 0 | 0 | 0 | 0 | 0 | 0 | 0 | 0 | 0 | 0 | 0 | 0 | 0 | 0 | 0 | 0 | – | – | – | – | – | – |
| Cell Periphery | 2 | 0 | 0 | 0 | 0 | 1 | 0 | 0 | 0 | 0 | 0 | 0 | 66 | 51 | 29 | 0 | 0 | 0 | 0 | 0 | 0 | 0 | 0 | 0 |
| Cytoplasm | 51 | 102 | 51 | 56 | 64 | 120 | 131 | 210 | 147 | 124 | 169 | 168 | 56 | 146 | 336 | 135 | 96 | 97 | 6 | 7 | 0 | 14 | 15 | 14 |
| Endoplasmic Reticulum | 8 | 40 | 17 | 3 | 1 | 8 | 5 | 3 | 3 | 2 | 1 | 4 | 243 | 183 | 92 | 13 | 9 | 2 | 61 | 81 | 43 | 118 | 103 | 101 |
| Endosome | 4 | 0 | 0 | 0 | 0 | 3 | 0 | 0 | 0 | 0 | 0 | 0 | 1 | 5 | 1 | 19 | 9 | 8 | 1 | 2 | 2 | 1 | 3 | 4 |
| Golgi | 0 | 0 | 0 | 1 | 0 | 0 | 0 | 0 | 0 | 0 | 0 | 0 | 4 | 1 | 0 | 1 | 1 | 2 | 1 | 0 | 2 | 2 | 0 | 1 |
| Mitochondria | 4 | 0 | 3 | 0 | 2 | 2 | 14 | 16 | 14 | 14 | 8 | 14 | 0 | 0 | 0 | 5 | 1 | 3 | 0 | 0 | 1 | 5 | 3 | 4 |
| Nucleus | 1 | 0 | 1 | 0 | 0 | 2 | 10 | 14 | 7 | 4 | 2 | 0 | 1 | 0 | 1 | 31 | 34 | 27 | 0 | 1 | 0 | 0 | 0 | 0 |
| Nuclear Periphery | 0 | 1 | 0 | 0 | 0 | 0 | 1 | 1 | 1 | 2 | 2 | 0 | 3 | 0 | 0 | 0 | 0 | 1 | 1 | 0 | 0 | 0 | 0 | 0 |
| Nucleolus | 2 | 0 | 0 | 1 | 0 | 0 | 0 | 0 | 0 | 0 | 0 | 0 | 0 | 0 | 0 | 0 | 0 | 0 | 0 | 0 | 0 | 0 | 0 | 0 |
| Peroxisomes | 0 | 0 | 0 | 0 | 0 | 0 | 0 | 0 | 0 | 0 | 0 | 0 | 0 | 1 | 0 | 0 | 0 | 0 | 0 | 0 | 0 | 0 | 1 | 0 |
| SpindlePole | 0 | 0 | 0 | 0 | 0 | 0 | 0 | 0 | 0 | 0 | 0 | 0 | 1 | 0 | 0 | 0 | 1 | 0 | 0 | 0 | 0 | 0 | 0 | 0 |
| Vac/Vac Membrane | 24 | 24 | 16 | 3 | 36 | 62 | 101 | 82 | 56 | 59 | 50 | 30 | 5 | 34 | 21 | 213 | 176 | 176 | 61 | 84 | 55 | 91 | 93 | 67 |
| Unique Cell Count | 90 | 150 | 81 | 61 | 88 | 174 | 205 | 281 | 182 | 163 | 206 | 190 | 331 | 366 | 451 | 337 | 261 | 272 | 137 | 183 | 110 | 241 | 230 | 205 |
| Labelled Cell Count | 96 | 167 | 88 | 64 | 103 | 198 | 263 | 327 | 228 | 205 | 233 | 216 | 404 | 431 | 481 | 417 | 327 | 316 | 137 | 183 | 110 | 241 | 230 | 205 |
Yeast GFP Assignment
Protein Abundance
| Screen | WT1 | WT2 | WT3 | RAP60 | RAP140 | RAP220 | RAP300 | RAP380 | RAP460 | RAP540 | RAP620 | RAP700 | HU80 | HU120 | HU160 | rpd3Δ_1 | rpd3Δ_2 | rpd3Δ_3 | AF100 | AF140 | AF180 |
|---|---|---|---|---|---|---|---|---|---|---|---|---|---|---|---|---|---|---|---|---|---|
| Mean Cell GFP Intensity (1e-4) | 7.7 | 9.2 | 7.2 | 8.3 | 8.0 | 6.8 | 5.8 | 5.8 | 5.7 | 5.2 | 5.3 | 5.0 | 15.5 | 10.3 | 7.4 | 7.7 | 9.1 | 8.9 | 7.2 | 7.3 | 8.6 |
| Std Deviation (1e-4) | 1.5 | 1.8 | 1.6 | 1.9 | 1.9 | 1.9 | 1.7 | 1.6 | 1.8 | 1.8 | 1.4 | 1.3 | 4.5 | 2.4 | 1.7 | 1.8 | 1.9 | 2.1 | 1.6 | 1.7 | 1.7 |
| Intensity Change (Log2) | – | – | – | 0.2 | 0.16 | -0.07 | -0.31 | -0.3 | -0.33 | -0.48 | -0.44 | -0.51 | 1.11 | 0.52 | 0.04 | 0.09 | 0.33 | 0.31 | 0.0 | 0.03 | 0.26 |
Localization Change
| Localization | RAP60 | RAP140 | RAP220 | RAP300 | RAP380 | RAP460 | RAP540 | RAP620 | RAP700 | HU80 | HU120 | HU160 | rpd3Δ_1 | rpd3Δ_2 | rpd3Δ_3 |
|---|---|---|---|---|---|---|---|---|---|---|---|---|---|---|---|
| Cortical Patches | 0 | 0 | 0 | 0 | 0 | 0 | 0 | 0 | 0 | 0 | 0 | 0 | 0 | 0 | 0 |
| Bud | 0 | 0 | 0 | 0 | 0 | 0 | 0 | 0 | 0 | 0 | 0 | 0 | 0 | 0 | 0 |
| Bud Neck | 0 | 0 | 0 | 0 | 0 | 0 | 0 | 0 | 0 | 0 | 0 | 0 | 0 | 0 | 0 |
| Bud Site | 0 | 0 | 0 | 0 | 0 | 0 | 0 | 0 | 0 | 0 | 0 | 0 | 0 | 0 | 0 |
| Cell Periphery | 0 | 0 | 0 | 0 | 0 | 0 | 0 | 0 | 0 | 4.4 | 3.6 | 0 | 0 | 0 | 0 |
| Cytoplasm | 3.9 | 1.4 | 0.9 | 0.1 | 2.1 | 3.1 | 2.1 | 3.4 | 4.9 | -8.5 | -3.8 | 2.1 | -3.7 | -4.2 | -4.4 |
| Endoplasmic Reticulum | -2.7 | -4.2 | -4.1 | -5.3 | 0 | -5.5 | -5.4 | -6.4 | -5.3 | 8.8 | 4.8 | -0.1 | -5.4 | -5.2 | 0 |
| Endosome | 0 | 0 | 0 | 0 | 0 | 0 | 0 | 0 | 0 | 0 | 0 | 0 | 0 | 0 | 0 |
| Golgi | 0 | 0 | 0 | 0 | 0 | 0 | 0 | 0 | 0 | 0 | 0 | 0 | 0 | 0 | 0 |
| Mitochondria | 0 | 0 | 0 | 0 | 0 | 1.2 | 1.4 | 0 | 1.1 | 0 | 0 | 0 | 0 | 0 | 0 |
| Nucleus | 0 | 0 | 0 | 0 | 0 | 0 | 0 | 0 | 0 | 0 | 0 | 0 | 2.4 | 3.1 | 2.5 |
| Nuclear Periphery | 0 | 0 | 0 | 0 | 0 | 0 | 0 | 0 | 0 | 0 | 0 | 0 | 0 | 0 | 0 |
| Nucleolus | 0 | 0 | 0 | 0 | 0 | 0 | 0 | 0 | 0 | 0 | 0 | 0 | 0 | 0 | 0 |
| Peroxisomes | 0 | 0 | 0 | 0 | 0 | 0 | 0 | 0 | 0 | 0 | 0 | 0 | 0 | 0 | 0 |
| SpindlePole | 0 | 0 | 0 | 0 | 0 | 0 | 0 | 0 | 0 | 0 | 0 | 0 | 0 | 0 | 0 |
| Vacuole | -2.6 | 3.0 | 2.6 | 4.6 | 1.7 | 1.8 | 2.6 | 0.8 | -0.8 | 0 | -2.7 | -4.9 | 7.1 | 7.6 | 7.1 |
External localization resources
Images






























Protein Concentration and Protein Localization Data
| R1 | R2 | R3 | ||||||||||||||||
|---|---|---|---|---|---|---|---|---|---|---|---|---|---|---|---|---|---|---|
| G1 Pre-START | G1 Post-START | S/G2 | Metaphase | Anaphase | Telophase | G1 Pre-START | G1 Post-START | S/G2 | Metaphase | Anaphase | Telophase | G1 Pre-START | G1 Post-START | S/G2 | Metaphase | Anaphase | Telophase | |
| Concentration | 7.3828 | 9.7039 | 8.8004 | 8.5327 | 10.0092 | 8.9912 | 6.8142 | 8.4231 | 8.0806 | 8.2201 | 7.8838 | 8.0127 | 9.631 | 11.1724 | 11.2454 | 12.269 | 11.7887 | 11.1976 |
| Actin | 0.0119 | 0 | 0.0001 | 0.0005 | 0.0001 | 0.0001 | 0.04 | 0.0001 | 0.0058 | 0.0004 | 0.0011 | 0.0095 | 0.0003 | 0.0001 | 0.0149 | 0.0002 | 0 | 0.002 |
| Bud | 0.0001 | 0.0002 | 0.0002 | 0.0007 | 0.0007 | 0.0002 | 0.0002 | 0.0001 | 0.0007 | 0.0002 | 0.0002 | 0.0001 | 0.0004 | 0.0002 | 0.0005 | 0.0002 | 0.0001 | 0.0002 |
| Bud Neck | 0.0008 | 0.0009 | 0.0007 | 0.0017 | 0.0014 | 0.0021 | 0.0006 | 0.0008 | 0.0026 | 0.0011 | 0.0013 | 0.0012 | 0.0012 | 0.0009 | 0.0011 | 0.0006 | 0.0003 | 0.0017 |
| Bud Periphery | 0.0007 | 0.0008 | 0.0007 | 0.0028 | 0.0013 | 0.0019 | 0.0005 | 0.0004 | 0.0014 | 0.0004 | 0.0009 | 0.0007 | 0.0025 | 0.001 | 0.001 | 0.001 | 0.0002 | 0.0014 |
| Bud Site | 0.0004 | 0.0007 | 0.0007 | 0.0007 | 0.0014 | 0.0003 | 0.0008 | 0.0008 | 0.0077 | 0.0002 | 0.0005 | 0.0002 | 0.0007 | 0.0009 | 0.0103 | 0.0003 | 0.0001 | 0.0003 |
| Cell Periphery | 0.0049 | 0.0141 | 0.0092 | 0.0079 | 0.0072 | 0.0127 | 0.0022 | 0.0115 | 0.005 | 0.002 | 0.0062 | 0.0063 | 0.0206 | 0.0085 | 0.0064 | 0.0039 | 0.001 | 0.0147 |
| Cytoplasm | 0.0184 | 0.0565 | 0.0333 | 0.0746 | 0.0989 | 0.0273 | 0.084 | 0.0973 | 0.1204 | 0.1601 | 0.0436 | 0.0386 | 0.0263 | 0.0494 | 0.0557 | 0.0458 | 0.0641 | 0.0185 |
| Cytoplasmic Foci | 0.0049 | 0.002 | 0.0029 | 0.0009 | 0.0057 | 0.0012 | 0.0213 | 0.0075 | 0.0136 | 0.0087 | 0.0025 | 0.0024 | 0.0012 | 0.0051 | 0.0148 | 0.0047 | 0.0026 | 0.0054 |
| Eisosomes | 0.0001 | 0 | 0 | 0 | 0 | 0 | 0.0003 | 0 | 0.0001 | 0 | 0 | 0 | 0 | 0 | 0.0002 | 0 | 0 | 0 |
| Endoplasmic Reticulum | 0.51 | 0.4466 | 0.4959 | 0.5464 | 0.4348 | 0.4805 | 0.6498 | 0.5503 | 0.6158 | 0.5138 | 0.4326 | 0.5983 | 0.6626 | 0.4857 | 0.5227 | 0.5935 | 0.2229 | 0.4603 |
| Endosome | 0.0604 | 0.0382 | 0.0527 | 0.0141 | 0.0736 | 0.0351 | 0.0517 | 0.0655 | 0.0615 | 0.1051 | 0.0445 | 0.0475 | 0.0279 | 0.0534 | 0.047 | 0.0913 | 0.0625 | 0.0445 |
| Golgi | 0.004 | 0.0011 | 0.0013 | 0.0005 | 0.0017 | 0.0007 | 0.0071 | 0.0009 | 0.0161 | 0.0218 | 0.002 | 0.0028 | 0.0007 | 0.001 | 0.0109 | 0.0052 | 0.0019 | 0.0016 |
| Lipid Particles | 0.0164 | 0.0095 | 0.009 | 0.0045 | 0.0031 | 0.003 | 0.0095 | 0.0151 | 0.0188 | 0.0102 | 0.011 | 0.0054 | 0.0099 | 0.0209 | 0.0195 | 0.0042 | 0.0996 | 0.0091 |
| Mitochondria | 0.0017 | 0.0003 | 0.0008 | 0.0005 | 0.001 | 0.0008 | 0.0033 | 0.0002 | 0.0056 | 0.0013 | 0.0007 | 0.002 | 0.0013 | 0.0004 | 0.0026 | 0.0015 | 0.002 | 0.0009 |
| None | 0.0074 | 0.0003 | 0.0004 | 0.0001 | 0.0004 | 0.0001 | 0.0029 | 0.0054 | 0.0021 | 0.0024 | 0.0005 | 0.0004 | 0.0005 | 0.0011 | 0.0022 | 0.0002 | 0.178 | 0.0006 |
| Nuclear Periphery | 0.0786 | 0.0329 | 0.04 | 0.0397 | 0.0265 | 0.0494 | 0.0366 | 0.0191 | 0.0161 | 0.0218 | 0.0392 | 0.0294 | 0.0674 | 0.048 | 0.0359 | 0.0337 | 0.0433 | 0.0506 |
| Nucleolus | 0.0006 | 0.0004 | 0.0006 | 0.0001 | 0.0078 | 0.0005 | 0.0002 | 0.0003 | 0.0009 | 0 | 0.0003 | 0.0001 | 0.0024 | 0.0004 | 0.0003 | 0.0001 | 0.0042 | 0.0004 |
| Nucleus | 0.0077 | 0.0055 | 0.0054 | 0.0035 | 0.0334 | 0.0122 | 0.0055 | 0.0026 | 0.003 | 0.0015 | 0.0064 | 0.0036 | 0.0128 | 0.0038 | 0.0042 | 0.0022 | 0.003 | 0.0061 |
| Peroxisomes | 0.0012 | 0 | 0 | 0 | 0.0001 | 0 | 0.0019 | 0.0001 | 0.0016 | 0.0001 | 0.0001 | 0.0014 | 0.0001 | 0.0001 | 0.0076 | 0.0001 | 0.0004 | 0.0008 |
| Punctate Nuclear | 0.001 | 0.0002 | 0.0003 | 0.0001 | 0.0004 | 0.0001 | 0.0022 | 0.0005 | 0.002 | 0.0002 | 0.0003 | 0.0002 | 0.0012 | 0.0003 | 0.0014 | 0.0002 | 0.0001 | 0.0032 |
| Vacuole | 0.2528 | 0.3786 | 0.3282 | 0.2845 | 0.2796 | 0.3468 | 0.0743 | 0.2158 | 0.0961 | 0.1363 | 0.3864 | 0.2343 | 0.1464 | 0.3014 | 0.2165 | 0.1998 | 0.2349 | 0.3509 |
| Vacuole Periphery | 0.0161 | 0.0113 | 0.0177 | 0.0161 | 0.0211 | 0.0247 | 0.0048 | 0.0057 | 0.003 | 0.0124 | 0.0196 | 0.0153 | 0.0137 | 0.0173 | 0.0244 | 0.0115 | 0.0789 | 0.0269 |
Sequencing Data
| R1 | R2 | |||||||||
|---|---|---|---|---|---|---|---|---|---|---|
| G1 Post-START | S/G2 | Metaphase | Anaphase | Telophase | G1 Post-START | S/G2 | Metaphase | Anaphase | Telophase | |
| Gene Expression | 50.0489 | 80.4639 | 87.5026 | 81.4939 | 32.1938 | 76.0012 | 129.575 | 136.5661 | 107.9797 | 98.1421 |
| Translational Efficiency | 1.0739 | 1.1628 | 1.0509 | 0.8279 | 0.9264 | 0.9006 | 1.0465 | 0.8586 | 1.0685 | 0.8211 |
Hit Data
| Dataset | Hit |
|---|---|
| Protein Concentration | ✔ |
| Protein Localization | ✘ |
| Gene Expression | ✔ |
| Translational Efficiency | ✘ |
Endocytosis
| Temp | Actin Patch (Sac6-tdTomato) | Cortical Patch (Sla1-GFP) | Late Endosome (Snf7-GFP) | Vacuole (Vph1-GFP) |
|---|---|---|---|---|
| 37℃ | ||||
| RT |
Cell Cycle Omics
CYCLoPs (Smf3-GFP)
| Gene / Allele | Actin Patch (Sac6-tdTomato) | Cortical Patch (Sla1-GFP) | Late Endosome (Snf7-GFP) | Vacuole (Sac6-tdTomato) |
|---|
| Gene | Images |
|---|
| Gene | Images |
|---|
Images are not yet available
Images are not yet available